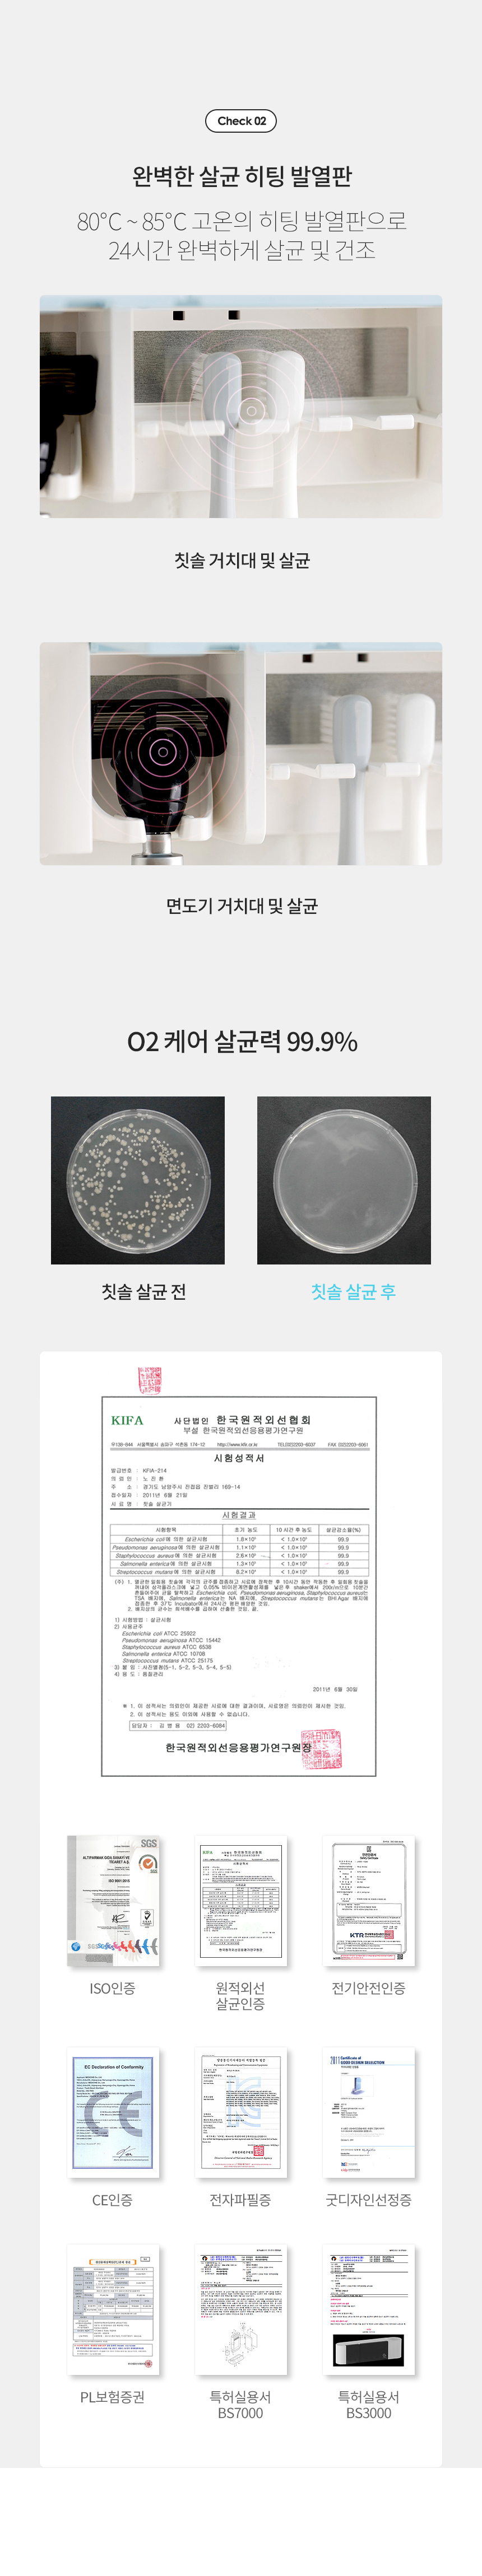

상품상세설명에 배송/교환/반품/취소 관련 안내가 기재된 경우 다음 안내사항보다 우선 적용됩니다.
| 배송정보 |
- 상품별로 상품 특성 및 배송지에 따라 배송유형 및 소요기간이 달라집니다.
- 일부 주문상품 또는 예약상품의 경우 기본 배송일 외에 추가 배송 소요일이 발생될 수 있습니다.
- 동일 브랜드의 상품이라도 상품별 출고일시가 달라 각각 배송될 수 있습니다.
- 도서 산간 지역은 별도의 배송비와 반품비가 추가될 수 있습니다.
- 상품의 배송비는 공급업체의 정책에 따라 다르오며 공휴일 및 휴일은 배송이 불가합니다.
|
| 취소/반품/교환 안내 |
- 신선식품의 경우 재판매가 불가능한 제품 특성상 단순변심 및 개인적 입맛 차이로 인한 반품은 불가능하며 제품 수령 후 문제가 있는 경우 이상부분 사진 촬영하여 수령하신 날짜 기준 2일 이내 연락해주셔야합니다.(기일은 업체별 상이할 수 있으니 수령즉시 연락 부탁드리겠습니다.)
- 무료배송상품의 경우 교환 또는 반품시 왕복 배송비가 부과될 수 있습니다.
- 상품하자 이외 사이즈, 색상교환 등 단순 변심에 의한 교환/반품 택배비 고객부담으로 왕복택배비가 발생합니다. (전자상거래 등에서의 소비자보호에 관한 법률 제17조(청약 철회등)9항에 의거 소비자의 사정에 의한 청약 철회 시 택배비는 소비자 부담입니다.)
- 결제완료 직후 즉시 주문취소는 "MY Page> 취소/교환/반품 신청"에서 직접 처리 가능합니다.
- 주문완료 후 재고 부족 등으로 인해 주문 취소 처리가 될 수도 있는 점 양해 부탁드립니다.
- 주문상태가 상품준비중인 경우 이미 배송을 했거나 포장을 완료했을 수 있어 직접 처리가 불가하오니 고객센터를 통해 문의 바랍니다.
- 반품/교환은 미사용 제품에 한해 배송완료 후 7일 이내 접수하여 주십시오.
- 임의반품은 불가하오니 반드시 고객센터나 "MY Page> 주문취소/교환/반품 신청"을 통해서 신청접수를 하시기 바랍니다.
- 상품하자, 오배송의 경우 택배비 무료로 교환/반품이 가능하지만 모니터의 색상차이, 착용감, 사이즈의 개인의 선호도는 상품의 하자 사유가 아닙니다.
- 단 위생용품 및 가전, 가구, 귀금속 등의 경우 취소/교환/반품 요청이 제한될 수 있습니다.
- 주문제작 상품 및 상품의 본품박스, 택 등이 제거되어 있을 경우 반품 / 교환이 불가능합니다.
- 고객 부주의로 상품이 훼손, 변경된 경우 반품 / 교환이 불가능 합니다.
- 취소/반품 대금환불이 지연 시 전자상거래법에 의거하여 환불지연 배상처리 절차가 진행됩니다.
|
| 반품/교환 불가능한 경우 |
- 제품을 사용 또는 훼손한 경우, 사은품 누락, 상품 TAG, 보증서, 상품 부자재가 제거 혹은 분실된 경우
- 밀봉포장을 개봉했거나 내부 포장재를 훼손 또는 분실한 경우(단, 제품확인을 위한 개봉 제외)
- 시간이 경과되어 재판매가 어려울 정도로 상품가치가 상실된 경우
- 고객님의 요청에 따라 주문 제작되어 고객님 외에 사용이 어려운 경우
- 배송된 상품이 설치가 완료된 경우(가전, 가구 등)
- 기타 전자상거래 등에서의 소비자보호에 관한 법률이 정하는 청약철회 제한사유에 해당하는 경우
|
| A/S 안내 |
- A/S 기준이나 가능여부는 브랜드와 상품에 따라 다르므로 관련 문의는 고객센터를 통해 부탁드립니다.
- 상품불량에 의한 반품, 교환, A/S, 환불, 품질보증 및 피해보상 등에 관한 사항은 소비자분쟁해결기준(공정거래위원회 고시)에 따라 받으실 수 있습니다.
|
본 상품정보(상품상세정보, 상품기본정보 등)의 내용은 판매자가 직접 등록한 정보입니다.
㈜삼아인터내셔날은 중개시스템만 제공하며 그 등록 내용에 대하여 일체의 책임을 지지 않습니다.